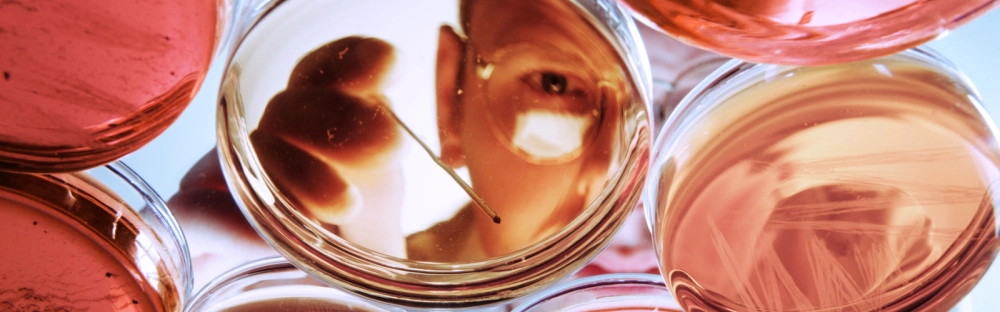
bef8f0742df8-Projekt-bez-nazwy-16-.png.webp

Articles & Opinions
Insights
Articles & Opinions
You will find here the articles written by Forvis Mazars Poland experts.
Strategia zrównoważonego rozwoju — na czym polega?

30 September 2025
Innowacyjne rozwiązania, nowoczesne technologie i szybki rozwój przedsiębiorstw wymuszają dbanie o ekosystem jako całość – dla przyszłości planety i późniejszych pokoleń. Zrównoważony rozwój jest rozwiązaniem odpowiedzialnym, a przede wszystkim korzystnym dla długoterminowego sukcesu.
Co warto wiedzieć o podatku VAT?

Podatek VAT to jedno z najważniejszych obciążeń fiskalnych, które dotyczy zarówno przedsiębiorców, jak i konsumentów. Poznanie zasad jego działania jest konieczne dla prawidłowego funkcjonowania firm oraz unikania kosztownych błędów. W Polsce VAT stanowi główne źródło dochodów budżetowych i obejmuje niemal wszystkie transakcje sprzedaży towarów i usług.
Dofinansowanie do zakupu okularów korygujących i soczewek kontaktowych

Długotrwała praca przed monitorem może negatywnie wpływać na wzrok – powodować zmęczenie oczu, pogorszenie ostrości widzenia i zaburzać koncentrację. Zgodnie z aktualnymi przepisami pracodawca ma obowiązek zapewnić pracownikom profilaktyczną opiekę medyczną. Obejmuje ona nie tylko badania lekarskie, ale także dofinansowanie do okularów korekcyjnych.
Najnowsze zmiany w badaniach medycyny pracy 2025 – co warto wiedzieć
Rosnące zagrożenie chorobami cywilizacyjnymi, takimi jak otyłość, cukrzyca, choroby krążenia, a także potrzeby związane z coraz powszechniejszą pracą zdalną i stresem zawodowym to czynniki, które wpłynęły na aktualizację przepisów dotyczących medycyny pracy.
Świadczenia urlopowe - zasady wypłaty, praktyczne aspekty

Okres urlopowy to czas odpoczynku, ale dla wielu pracowników stanowi również okazję do otrzymania dodatkowego wsparcia finansowego od pracodawcy. Mowa o świadczeniu urlopowym, czyli jednorazowym dodatku pieniężnym wypłacanym w związku z urlopem wypoczynkowym. Kwestie świadczenia urlopowego reguluje ustawa z dnia 4 marca 1994 r. o zakładowym funduszu świadczeń socjalnych (t.j. Dz. U. z 2022 r. poz. 923 - dalej „ustawa”).
Czym jest Krajowy System e-Faktur (KSeF)?

Krajowy System e-Faktur (KSeF) to platforma wprowadzona przez Ministerstwo Finansów umożliwiająca wystawianie i udostępnianie faktur ustrukturyzowanych.
Dopłata do wypoczynku dzieci pracowników - co powinien wiedzieć pracodawca w 2025 roku?

Dopiero co zakończył się rok szkolny - dla dzieci to czas radości, beztroski i wakacyjnych przygód. Dla wielu rodziców oznacza to jednak dodatkowe wyzwania organizacyjne i finansowe. Koszty kolonii, półkolonii, wyjazdów zorganizowanych czy opieki nad dziećmi potrafią znacząco obciążyć domowy budżet.
Ceny transferowe pod lupą fiskusa – 2024 rokiem rekordowych doszacowań

W ostatnich latach ceny transferowe stały się jednym z kluczowych obszarów zainteresowania organów podatkowych. Podmioty z grup kapitałowych coraz częściej zderzają się z kontrolami, których skutkiem są wielomilionowe doszacowania dochodu. Przyglądamy się temu, jak zmienia się podejście fiskusa, co pokazują najnowsze dane z kontroli oraz w jaki sposób firmy mogą skutecznie się zabezpieczyć.
Praktyczne wyzwania związane z wdrożeniem JPK_KR_PD – aspekty księgowe

W niniejszym artykule przedstawiamy praktyczne przykłady wyzwań ewidencji księgowej, z którymi mogą spotkać się jednostki podczas procesu wdrożenia JPK_KR_PD (Jednolitego Pliku Kontrolnego – Księgi Rachunkowe – Podatek Dochodowy). Zostały one zdefiniowane na podstawie naszego doświadczenia we współpracy z klientami, a ich syntetyczne ujęcie może stanowić wsparcie przy planowaniu procesu wdrożenia w Państwa firmie.
Zarządzanie ryzykiem ESG - wdrożenie wytycznych Europejskiego Urzędu Nadzoru Bankowego w sektorze bankowym

Poniżej prezentujemy najważniejsze informacje dotyczące wytycznych Europejskiego Urzędu Nadzoru Finansowego (EBA) dotyczące zarządzania ryzykami środowiskowymi, społecznymi i ładu korporacyjnego (ESG). Zgodnie z przedstawionym haromonogramem, wytyczne będą obowiązywać europejskie banki od 11 stycznia 2026 r. z wyjątkiem małych i nieskomplikowanych instytucji.